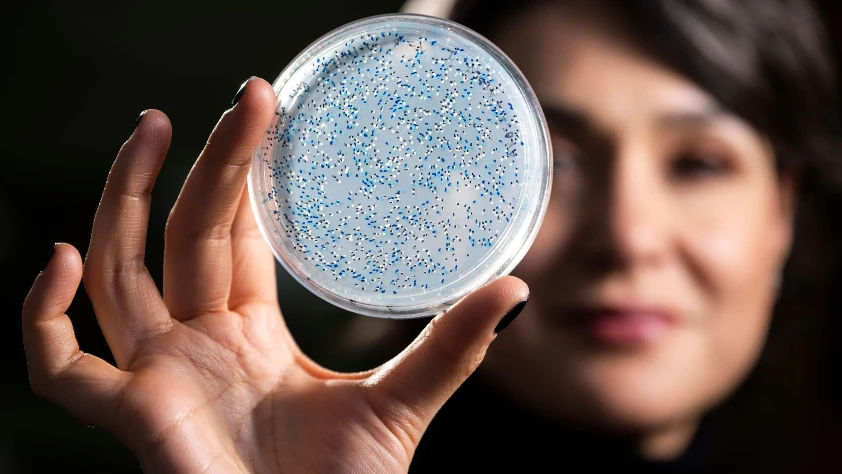
NASA'nın uzayda yaşam arayışı: 3.2 milyar yıllık enzim canlandırıldı

- Son Dakika
- Gündem
- Ekonomi
- Finans Ekstra+
- Yazarlar
- Sektörel
- Dünya
- Kültür-Sanat
- Teknoloji
- FOTOĞRAF GALERİSİ
- VİDEO GALERİSİ
- e-Gazete
Gelişmelerden haberdar olmak için İstanbul Ticaret Haberleri uygulamasını indirin
Wisconsin-Madison Üniversitesi'ndeki bakteriyoloji profesörü Betül Kaçar ve doktora adayı Holly Rucker, günümüzdeki enzimlerden geriye giderek milyarlarca yıl önce var olmuş olabilecek versiyonlarını yeniden oluşturdu. Araştırmacılar bu antik enzimleri canlı mikroplara yerleştirerek söz konusu moleküler sistemlerin nasıl işlediğini doğrudan gözlemledi ve modern muadilleriyle karşılaştırdı. Kaçar çalışmanın önemini tek bir cümleyle özetledi: "Bu gezegendeki yaşamın tonunu belirleyen bir enzimi seçtik ve ardından tarihini inceledik. Nitrojenaz olmasaydı, bildiğimiz anlamda yaşam olmazdı."
FOSİL YETERSİZLİĞİNE YENİ ÇÖZÜM
On yıllardır araştırmacılar, erken yaşamın hikayesini aydınlatmak için eski kayalara ve fosillere başvuruyor. Ancak milyarlarca yıl öncesine ait iyi korunmuş örnekler son derece nadir ve ulaşılması güç. Kaçar ve Rucker, laboratuvar ortamında yeniden oluşturmanın bu eksiği gidereceğini savunuyor. Rucker, 3 milyar yıl önceki Dünya'nın bugünkünden çok farklı olduğunu vurgulayarak o dönemde atmosferde çok daha fazla karbondioksit ve metan bulunduğuna, yaşamın ise esas olarak oksijensiz ortamda yaşayan anaerobik mikroplardan oluştuğuna dikkat çekiyor.
İZOTOPİK İMZA MILYARLARCA YIL BOYUNCA DEĞİŞMEDİ
Enzimler fosilleşmez; ancak faaliyetleri kimyasal izler bırakabilir. Nitrojenaz özelinde azot fiksasyonu süreci, eski kayalarda korunabilen kendine özgü izotopik desenler üretiyor. Bilim insanları uzun süredir bu enzimin geçmişte de günümüzdekiyle aynı izotopik imzaları ürettiğini varsayıyordu. Rucker bu varsayımı sorguladı ve araştırmacıların jeolojik kanıtları yanlış yorumluyor olabileceğini öne sürdü. Sonuç çarpıcı çıktı: "Eski çağlarda gördüğümüz izler bugün de aynı; bu da bize enzimin kendisi hakkında çok daha fazla bilgi veriyor."
Ekip, yeniden oluşturulan antik nitrojenazın DNA diziliminin modern versiyonlardan farklılaşmasına karşın izotopik imzadan sorumlu temel mekanizmanın milyarlarca yıl boyunca tutarlı kaldığını keşfetti. Rucker, enzimin diğer bölümleri evrim sürecinde değişirken bu özel özelliğin neden sabit kaldığını araştırmayı planlıyor.
UZAYDA YAŞAM ARAYIŞINA YENİ ÇERÇEVE
Araştırma, NASA tarafından finanse edilen ve Kaçar'ın liderliğini üstlendiği astrobiyoloji konsorsiyumu MUSE kapsamında yürütülüyor. Çeşitli kurumlardan astrobiyologları ve jeologları bir araya getiren MUSE, Dünya'daki mikrobiyoloji ve moleküler biyolojiye dair yeni evrimsel bulgular aracılığıyla NASA uzay görevlerini desteklemeyi hedefliyor. Nitrojenazdan türetilen izotopların artık Dünya'da güvenilir bir biyolojik imza olarak tanımlanmasıyla MUSE, diğer gezegenlerdeki benzer sinyalleri değerlendirmek için çok daha sağlam bir çerçeveye kavuştu.
Kaçar, çalışmanın evrensel boyutunu şöyle ifade etti: "Astrobiyologlar olarak evrendeki yaşamı anlamak için gezegenimizi anlamaya güveniyoruz. Yaşam arayışı burada, evimizde başlıyor ve evimiz 4 milyar yaşında. Önümüzdeki yaşamı ve başka yerlerdeki yaşamı anlamak istiyorsak, bizden önceki yaşamı anlamamız gerekiyor."